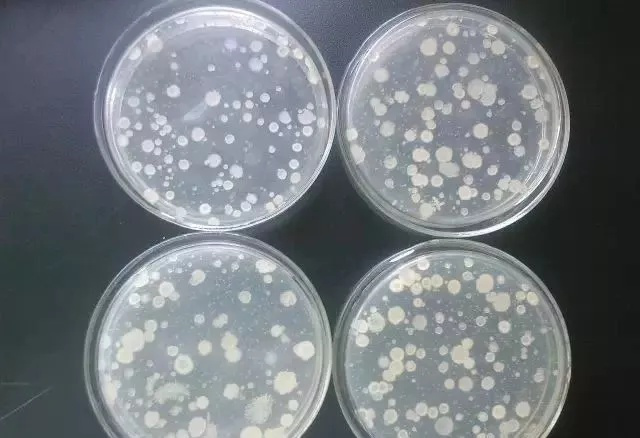

洗衣机洗完衣服千万不能做这个动作,小心细菌霉菌滋生
来源:益康信息部
日期:2020-02-26
长期未清洗的洗衣机,会产生霉菌等多种细菌,甚至会引发慢性荨麻疹。洗衣机最脏的地方是在内桶跟外桶中间的夹层。专家提醒:洗完衣服30分钟后再关上盖子,并定期进行清洗消毒!洗衣机会滋生霉菌是真的吗?中央经济频道《是真的么》栏目组到拥有国家授予检测资质的第三方检测机构,在工作人员的帮助下,对一周未使用、两周未使用、两个月未使用的洗衣机进行入户采样。
从洗衣水的检测结果来看,两个月未用、两周未用的洗衣机,果然都长出了不同程度的霉菌。连一周未用的洗衣机竟然也生出了霉菌,看来洗衣机确实是一个容易滋生霉菌的地方。那么,这些霉菌会对人体造成什么样的影响呢?第二炮兵总医院皮肤科主任医师杨维玲说:这些细菌对人体会造成危害,引起皮肤疾病。如果把内衣内裤都在洗衣机里洗,也不能排除通过洗衣服来传染上霉菌等疾病,还有一些皮肤过敏性疾病,如慢性荨麻疹等。霉菌对孩子的影响远高于成年人。
霉菌感染一般都跟免疫功能有关系,有的人免疫功能强,可能受感染的机率就小。但孩子的免疫功能很弱,所以要非常注意。在生活中,大家能看得到的洗衣机的部分大多都觉得很干净,是因为洗衣机最脏的地方在内桶跟外桶中间的夹层,平时用肉眼是看不到的,只有把上盖这个减震盒全部拆掉以后才能看到里面的脏东西。除此之外,洗衣机的下水回路也是一个容易滋藏污垢的地方。

洗衣机的正确使用及保养方法1、每次洗完衣服,大概30分钟以后再盖上盖子,避免桶内潮湿,给细菌提供疯狂滋长的环境;2、每次用完之后把里面的过滤网跟过滤盒拿出来,清洗一下;3、定期请专业人员进行清洗、消毒。









